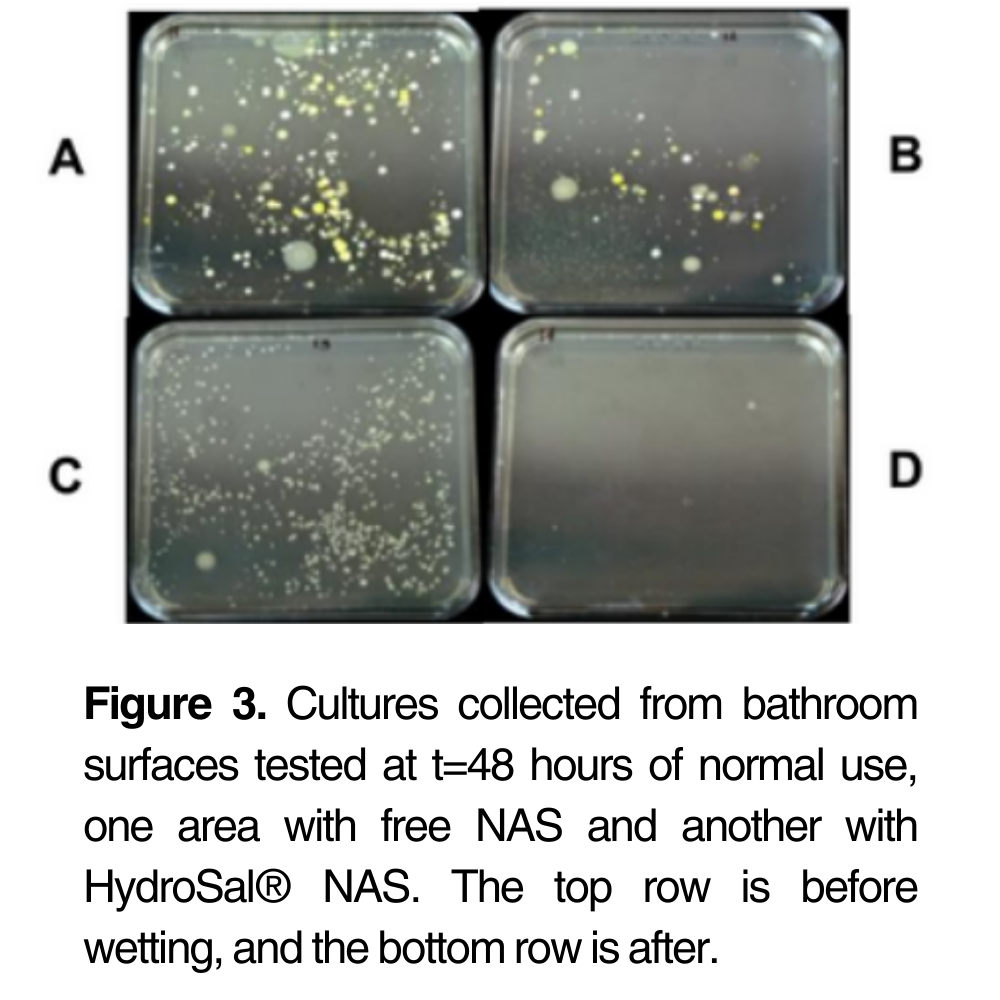
HydroSal® Natural Antiseptic

HydroSal® Natural Antiseptic
Salvona ID: 8419-02
HydroSal® Natural Antiseptic (NAS) is a revolutionary, alcohol-free solution designed to provide extended protection against microbes. Powered by natural plant extracts with proven antiseptic and antifungal properties, this advanced delivery system ensures a time-released action that activates precisely when it’s needed. Its unique encapsulation technology enhances retention on skin and surfaces, offering superior efficacy compared to traditional formulations.
With its ability to release a burst of protection in wet conditions, HydroSal® NAS is ideal for leave-on skincare products and high-touch surfaces. This innovative solution not only delivers powerful, broad-spectrum antimicrobial activity but also minimizes formulation complexity, making it a cost-effective and sustainable choice for modern hygiene needs. Whether for personal care or environmental protection, HydroSal® NAS sets a new standard for natural, long-lasting microbial defense.
All website orders will have a minimum of 90 days of shelf-life remaining
Product documentation is available to registered customers.
Login to Access DocumentsINCI